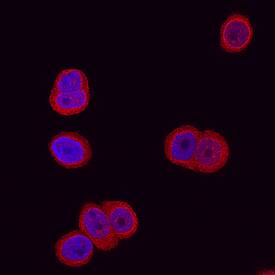
Glucosaminyl (N-acetyl) Transferase 1/GCNT1 antibody in HT-29 human cell line by Immunocytochemistry (ICC).

Human Glucosaminyl (N-acetyl) Transferase 1/GCNT1 Antibody
R&D Systems, part of Bio-Techne | Catalog # AF7248


Key Product Details
Species Reactivity
Validated:
Cited:
Applications
Validated:
Cited:
Label
Antibody Source
Product Specifications
Immunogen
Arg33-His428
Accession # NP_001481
Specificity
Clonality
Host
Isotype
Scientific Data Images for Human Glucosaminyl (N-acetyl) Transferase 1/GCNT1 Antibody
Detection of Human Glucosaminyl (N‑acetyl) Transferase 1/GCNT1 by Western Blot.
Western blot shows lysates of SW480 human colorectal adenocarcinoma cell line, TT human medullary thyroid cancer cell line, and Capan-1 human pancreatic adenocarcinoma cell line. PVDF membrane was probed with 1 µg/mL of Sheep Anti-Human Glucosaminyl (N-acetyl) Transferase 1/GCNT1 Antigen Affinity-purified Polyclonal Antibody (Catalog # AF7248) followed by HRP-conjugated Anti-Sheep IgG Secondary Antibody (Catalog # HAF016). A specific band was detected for Glucosaminyl (N-acetyl) Transferase 1/GCNT1 at approximately 50 kDa (as indicated). This experiment was conducted under reducing conditions and using Immunoblot Buffer Group 1.Glucosaminyl (N-acetyl) Transferase 1/GCNT1 in HT‑29 human cell line.
Glucosaminyl (N-acetyl) Transferase 1/GCNT1 was detected in immersion fixed HT-29 human colon adenocarcinoma cell line using Sheep Anti-Human Glucosaminyl (N-acetyl) Transferase 1/GCNT1 Antigen Affinity-purified Polyclonal Antibody (Catalog # AF7248) at 15 µg/mL for 3 hours at room temperature. Cells were stained using the NorthernLights™ 557-conjugated Anti-Sheep IgG Secondary Antibody (red; Catalog # NL010) and counterstained with DAPI (blue). Specific staining was localized to plasma membrane and cytoplasm. View our protocol for Fluorescent ICC Staining of Cells on Coverslips.Glucosaminyl (N-acetyl) Transferase 1/GCNT1 in Human Bladder Cancer Tissue.
Glucosaminyl (N-acetyl) Transferase 1/GCNT1 was detected in immersion fixed paraffin-embedded sections of human bladder cancer tissue using Sheep Anti-Human Glucosaminyl (N-acetyl) Transferase 1/GCNT1 Antigen Affinity-purified Polyclonal Antibody (Catalog # AF7248) at 3 µg/mL overnight at 4 °C. Tissue was stained using the Anti-Sheep HRP-DAB Cell & Tissue Staining Kit (brown; Catalog # CTS019) and counterstained with hematoxylin (blue). Specific staining was localized to plasma membrane in smooth muscle cells. View our protocol for Chromogenic IHC Staining of Paraffin-embedded Tissue Sections.Applications for Human Glucosaminyl (N-acetyl) Transferase 1/GCNT1 Antibody
Immunocytochemistry
Sample: Immersion fixed HT‑29 human colon adenocarcinoma cell line
Immunohistochemistry
Sample: Immersion fixed paraffin-embedded sections of human bladder cancer tissue
Western Blot
Sample: SW480 human colorectal adenocarcinoma cell line, TT human medullary thyroid cancer cell line, and Capan‑1 human pancreatic adenocarcinoma cell line
Formulation, Preparation, and Storage
Purification
Reconstitution
Formulation
Shipping
Stability & Storage
- 12 months from date of receipt, -20 to -70 °C as supplied.
- 1 month, 2 to 8 °C under sterile conditions after reconstitution.
- 6 months, -20 to -70 °C under sterile conditions after reconstitution.
Background: Glucosaminyl (N-acetyl) Transferase 1/GCNT1
Mucin-type O-glycans are initiated with an O-GalNAc attachment to a serine or threonine in a polypeptide. The O-GalNAc residues are subsequently extended by various glycosyltransferases resulting in different types of O-glycans. Most O-glycans contain the core 1 structure, Gal beta1-3GalNAc. Glucosaminyl (N-acetyl) Transferase 1 (GCNT1) converts the core 1 O-glycan to core 2 O-glycan, Gal beta1-3(GlcNAc beta1-6)GalNAc, via the addition of a GlcNAc residue (1, 2). Various ligand carbohydrates can be formed from core 2 branched oligosaccharides. For example, sialyl Lex in mucin‑type glycoproteins of blood cells can be formed from core 2 branched oligosaccharides (3, 4). The expression of GCNT1 was found to be associated with the progression of various types of cancer (5, 6, 7). The enzymatic activity of the recombinant GCNT1 is measured using a phosphatase-coupled method (8).
References
- Bierhuizen, M.F. (1993) Genes & Development 7:468.
- Yeh, J.C. et al. (1999) J. Biol. Chem. 274:3215.
- Hemmerich, S. et al. (1995) J. Biol. Chem. 270:12035.
- Wilkins, P.P. et al. (1996) J. Biol. Chem. 270:18732.
- Shimodaira, K. et al. (1997) Cancer Res. 57: 5201.
- Hatakyama, S. et al. (2010) Int. J. Cancer 127:1052.
- St Hill, C.A. et al. (2009) BMC Cancer 9:79.
- Wu, Z.L. et al. (2011) Glycobiology 21:727.
Long Name
Alternate Names
Gene Symbol
UniProt
Additional Glucosaminyl (N-acetyl) Transferase 1/GCNT1 Products
Product Documents for Human Glucosaminyl (N-acetyl) Transferase 1/GCNT1 Antibody
Product Specific Notices for Human Glucosaminyl (N-acetyl) Transferase 1/GCNT1 Antibody
For research use only